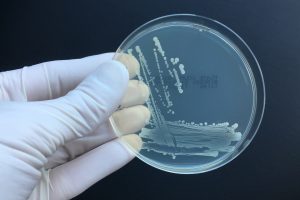

Jörg Brünke e.K
Dr. Brünke MTC – Microbiological Testing Competence
Valznerweiherstraße 15
90480 Nürnberg
Telefon: 0911/41844967
Email: info(at)bruenke-mtc.de
Website: www.bruenke-mtc.de
AG Nürnberg HRA 18059
Gerichtsstand Nürnberg
Finanzamt Nürnberg-Süd
Ust-ID: DE 315 605 763
Geschäftsführer
Dr. Jörg Brünke
Inhaltlich Verantwortlicher gemäß § 5 DDG (ehemalsTMG):
Dr. rer. nat. Jörg Brünke
(Anschrift wie oben)
Haftungshinweis:
Trotz sorgfältiger inhaltlicher Kontrolle übernehmen wir keine Haftung für die Inhalte externer Links.
Für den Inhalt der verlinkten Seiten sind ausschließlich deren Betreiber verantwortlich.